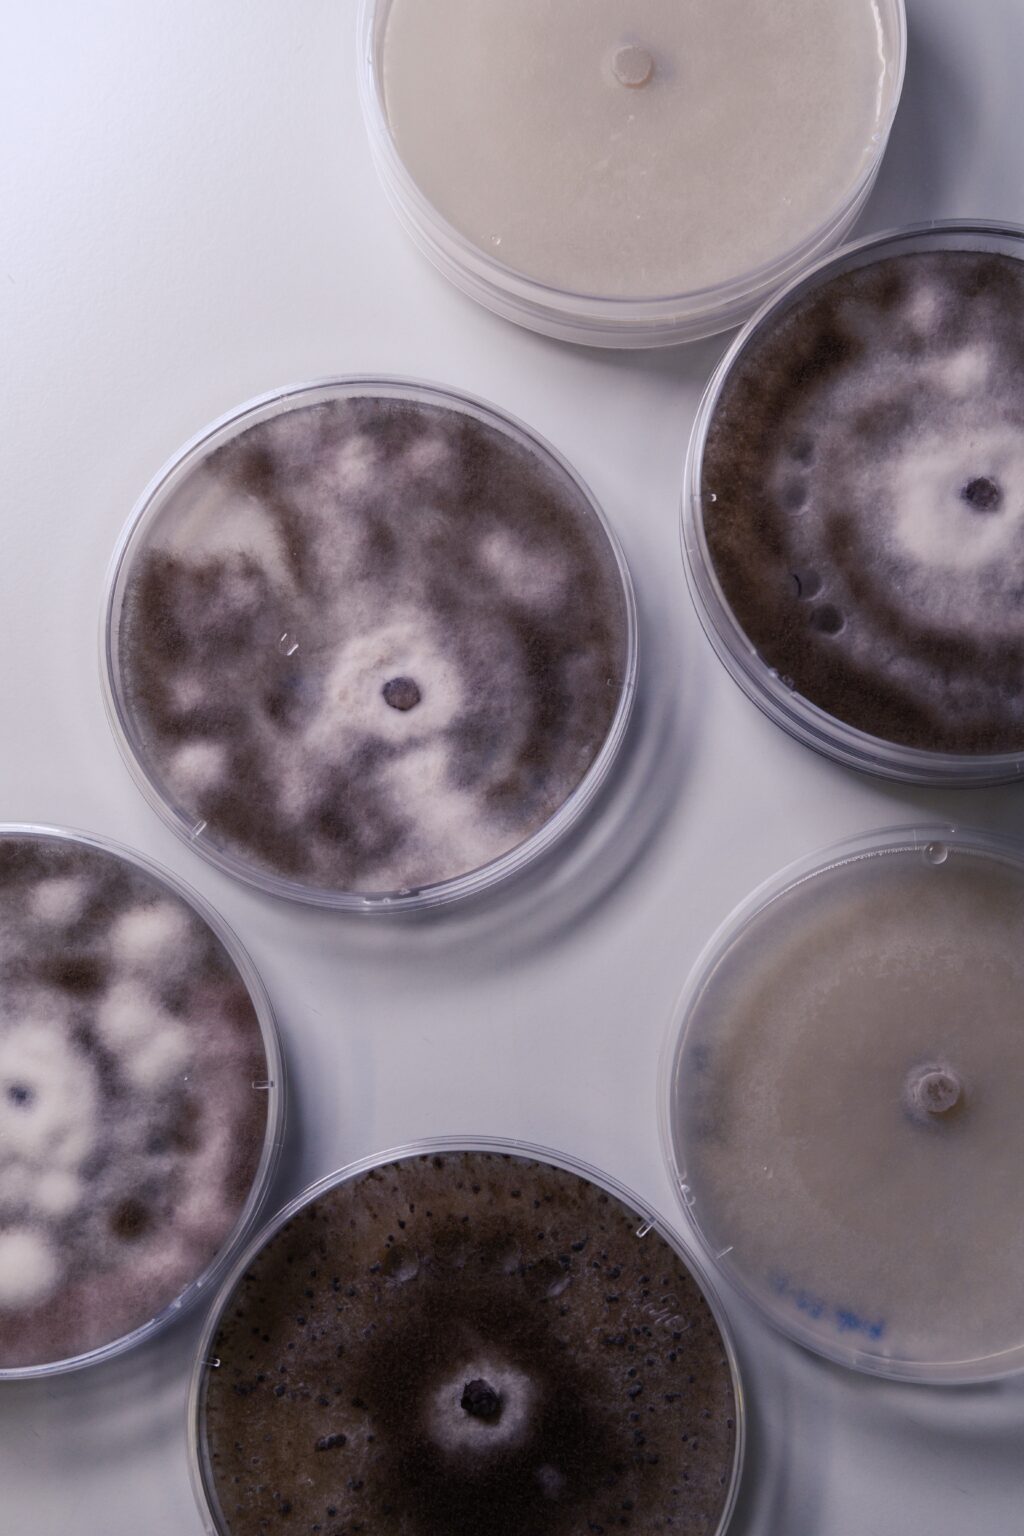

Warranties
180-Day Plus Warranty
- Mechanical coverage is $500
- Structural coverage is $2,000
- 180-Days from inspection or 22 days after closing (whichever comes later)
- $0 deductible
- Age for Appliances and HVAC is under 11 years old
MECHANICAL COVERAGE SUMMARY:
- Plumbing: Water lines, faucets, water heaters, drain lines, gas lines, irrigation system lines.
- Electrical: Main service panel, secondary service panel, and wiring.
- Appliances: Kitchen Appliances including and limited to oven, range, dishwasher, built-in microwave, trash compactor, refrigerator, washer/dryer and garbage disposal.
- Heating/Air: Furnace, Boiler Systems, Air Conditioner, and Thermostats.
- Pool/Spa: Pumps, motors, and heaters. Garage Door Openers and Sump Pumps.
STRUCTURAL COVERAGE SUMMARY:
Poured Concrete & Block wall foundations. Floor joists, bottom & top plates, and wall members. Roof leak repair (does not include replacement of bad shingles), load bearing walls, attached garage doors.


SewerGard Plus
- Water supply line coverage up to $2,000 in repairs ($300 deductible)
- Waste line coverage up to $2,000 in repairs ($300 deductible)
- If there is a free and clear sewer scope, the warranty goes from 180 days to 12 months! (Buyers send us the sewer scope report and/or video after the 90/180 days)
Coverage
During the agreement term, only the directly affected portions of the following components are covered against failure due to normal wear and tear:
- Exterior Water Supply Line- The water line is the single lateral water service line from the point of the water utility’s connection to the point of the water meter or main shut offline inside the home. The water line also includes well water lines, excluding those exceeding five feet under the surface level of the yard.
- Exterior Sewer/Septic Waste Line- The waste line is the single lateral sewer service line from the point of the home’s exterior wall to the point of connection to the sewer/septic utility’s wastewater collection system.
MoldSafe
- Mold chemical treatment coverage up to $2,000 ($300 deductible)
- 180-Days from inspection or 22 days after closing (whichever comes later)
Coverage
During the agreement term, the following conditions are covered:
- New visible mold- During the course of your full home inspection and in your home inspection report, if there were no visible mold or moisture issues listed, this agreement only covers the remediation (removal) of visible mold on surfaces permanently installed in the subject property that was visually seen by the inspector at the time of inspection.
- Covered Repairs- This agreement covers only repairs as in aggregate. Only new visible mold growth that occurs after the date of the inspection is covered. This agreement does not cover repairs to components that need to be replaced but rather just covers their removal. Many surfaces can be treated and cleaned without such removal. This policy does not cover mold resulting from insurable events including but not limited to floods, rain/water intrusion, or any other peril. This is not a homeowner’s insurance policy.
5 Year Warranty
- Roof leak coverage is $3,000
- $500 deductible per leak
NXT Structural Warranty
- 12 months from the inspection date
- $2,000 deductible per claim and the next $5,000 for the structural issue is covered
- Total coverage is $100,000 in structural coverage for the 12 months
Coverage Details
Examples of Covered Occurrences
Examples of Non-Covered Occurrences
Radon Plus Warranty
- 12 months coverage if there is an active radon mitigation system installed and original test comes back safe (under 4.0 PCi/L)
- 120 days from original test date if there is no mitigation system installed
- $250 deductible and RWS pays $1,200 towards a mitigation system
Coverage
This plan is only applicable to properties where both of the following conditions are met:
- This test is the first and only test done in the preceding 6-month period at this property.
- The results came back under 4.0 PCi/L (200 Bq/m in Canada).
Covered Repairs
Beginning the day of the radon test and extending for a period of 120 days thereafter, RWS guarantees your radon levels to be under 4.0 PCi/L (200 Bq/m in Canada). If at any time during that 120 day period (or an extension period as defined below) another test is performed by a duly licensed professional and the levels come back at 4.0 PCi/ L or higher (200 Bq/m in Canada), RWS will pay the cost of mitigation up to $1200 and after a deductible of $250 is met. When a second test is performed, RWS reserves the right to perform an additional test to confirm the validity of such results at its own expense. Such a test will be either a CRM (Continuous Radon Monitor) or an Alpha Track long term test, the results of which will be accepted by all parties.


How to Submit an Inspection Warranty Claim
To submit a claim for a warranty with the full home inspection you can go to www.SubmitYourClaim.net and create an account by clicking “Create Account” tab. Once logged into your account you will click the “New Claim” button (at the bottom of the page) and submit your claim. You will need to upload an itemized repair estimate from a licensed contractor that states the (1) cause of failure as well as (2) parts and labor broken out for each issue. You will also upload your inspection report and some basic info on the home and contact info. If the claim is for an appliance or HVAC system we will need the manufacture, model # and serial # from the unit that was inspected. See below for further items that a claim needs to be on the estimate. Your warranty is based on the date of the full home inspection.
Claims Team Contact Info
- claimsupport@inspectorservicesgroup.com
- 833-521-7901
During the agreement term, only the directly affected portions of the following components are covered against failure due to normal wear and tear:
- Exterior Water Supply Line- The water line is the single lateral water service line from the point of the water utility’s connection to the point of the water meter or main shut offline inside the home. The water line also includes well water lines, excluding those exceeding five feet under the surface level of the yard.
- Exterior Sewer/Septic Waste Line- The waste line is the single lateral sewer service line from the point of the home’s exterior wall to the point of connection to the sewer/septic utility’s wastewater collection system.
Roof Leak
- Number of leaks
- Location of leak(s)
- Square footage of leak(s)
- Cause of each leak(e.g. wear & tear, age or something else in their professional opinion)
- Price breakdown for materials separated by leak(s)
- Price for labor separated by leak(s)
For HVAC/Electrical/Appliances/Plumbing
- Diagnosis/Initial Failure(e.g. a brief description of the failure)
- Specific Cause of Failure(e.g. wear & tear, age or something else in their professional opinion)
- Itemized Cost of Parts
- Cost/ Hours of Labor
- Brand, Model & Serial Numbers of failed Unit (for appliances only)
For Structural Claims
- Diagnosis/Initial Failure(e.g. a brief description of the failure)
- Specific Cause of Failure(e.g. wear & tear, age, or something else in their professional opinion)
- Description of what’s been done to address the failure
- Itemized Cost of Parts
- Cost/Hours of Labor
MoldSafe
- Location of visible mold(must be visible)
- Square footage of area treated
- What is being removed or cleaned
- Cause of mold(in their professional opinion)
- Name of chemical
- Cost for chemical per unit
- Cost of labor to apply chemical
SewerGard
- Diagnosis(e.g. brief description of failure – is a break/belly/clog)
- Location of break(e.g. inside or outside etc…)
- Length of broken portion of underground pipe
- Cause of break(e.g. wear & tear, age, or something else in their professional opinion)
- Parts and labor cost broken out
Radon Protection Plan
- The report for the initial testing done with results under 4.0 PCi/L (200 Bq/m)
- The report from a recent testing done with results above 4.0 PCi/L (200 Bq/m)
Client Testimonials
Posted on GoogleTrustindex verifies that the original source of the review is Google. Tyler was very informative and in depth with his explanation of what he was inspecting. He made sure I had an understanding of what the issues were and how to move forward. Definitely would recommend him for future inspections.Posted on GoogleTrustindex verifies that the original source of the review is Google. Great experience using Champia for my pre-drywall inspection. They made the process easy and the inspector was extremely knowledgeable.Posted on GoogleTrustindex verifies that the original source of the review is Google. They did an excellent job and they work with youPosted on GoogleTrustindex verifies that the original source of the review is Google. I have use Champia on 2 separate occasions to inspect houses i was trying to purchase. After first inspection I had to walk away. The second one is still pending. I do appreciate how they take it seriously and they're input on moving forwardPosted on GoogleTrustindex verifies that the original source of the review is Google. Scott was professional and thorough. Had the report next day with marked photos. Can only recommend.Posted on GoogleTrustindex verifies that the original source of the review is Google. Very professional, courteous and knowledgeable.Posted on GoogleTrustindex verifies that the original source of the review is Google. As a Real Estate Professional, I have had the opportunity to do business with Champia Real Estate Inspections on behalf of clients over the past decade. Their expertise and knowledge is why they are a preferred source for home inspections. My clients have been satisfied with the services they’ve received from Champia. The reports are detailed, yet easy to understand. My clients love Champia!
